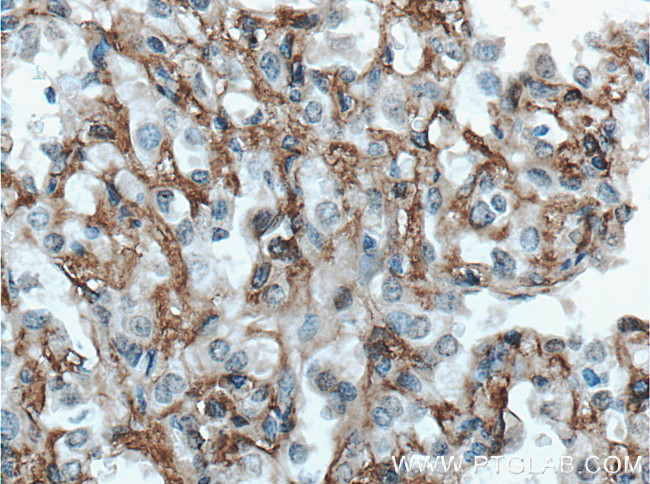
HAI-1 Antibody in Immunohistochemistry (Paraffin) (IHC (P))

Search
Proteintech
HAI-1 Polyclonal Antibody
{{$productOrderCtrl.translations['antibody.pdp.commerceCard.promotion.promotions']}}
{{$productOrderCtrl.translations['antibody.pdp.commerceCard.promotion.viewpromo']}}
{{$productOrderCtrl.translations['antibody.pdp.commerceCard.promotion.promocode']}}: {{promo.promoCode}} {{promo.promoTitle}} {{promo.promoDescription}}. {{$productOrderCtrl.translations['antibody.pdp.commerceCard.promotion.learnmore']}}
产品信息
27593-1-AP
种属反应
宿主/亚型
分类
类型
抗原
偶联物
形式
浓度
规格
纯化类型
保存液
内含物
保存条件
运输条件
产品详细信息
Immunogen sequence: SMERRHPVC SGTCQPTQFR CSNGCCIDSF LECDDTPNCP DASDEAACEK YTSGFDELQR IHFPSDKGHC VDLPDTGLCK ESIPRWYYNP FSEHCARFTY GGCYGNKNNF EEEQQCLESC RGISKKDVFG LRREIP (307-441 aa encoded by BC004140)
靶标信息
The protein encoded by this gene is a member of the Kunitz family of serine protease inhibitors. The protein is a potent inhibitor specific for HGF activator and is thought to be involved in the regulation of the proteolytic activation of HGF in injured tissues. Alternative splicing results in multiple variants encoding different isoforms.
仅用于科研。不用于诊断过程。未经明确授权不得转售。
篇参考文献 (0)
生物信息学
蛋白别名: HAI-1; HAI-1B; Hepatocyte growth factor activator inhibitor type 1; Kunitz-type protease inhibitor 1; serine protease inhibitor, Kunitz type 1; unnamed protein product
基因别名: HAI; HAI1; MANSC2; SPINT1; UNQ223/PRO256
UniProt ID: (Human) O43278
Entrez Gene ID: (Human) 6692